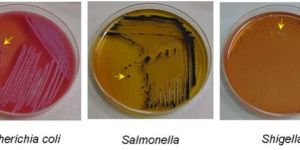
MICROBIOLOGICAL TESTING IN FOOD AND FOOD PRODUCTS

Microbiology Testing Services
Get Price Quote
Spectro has been providing world-class services to various industries for Microbiology Testing from past several years. We have a renowned name in the market for providing efficient services with accurate results. We ensure that the products are quality wise safe and are manufactured as per the requirements of specified Standards.
Our cutting-edge microbiological testing facilities are available for food and agro products, cosmetics, water, and pharmaceutical products like medical devices, surgical dressing and various other consumable materials. Our experienced personnel carry out tests for a complete range of potentially harmful microorganisms which include various species of pathogenic bacteria and fungi. Microbiological tests for factory hygiene purposes for air, water and surfaces (swab test) are also carried out by us. By making use of our services, you can be sure about the purity of your products and safeguard your brand name that could help you to build a strong bond with you clients.
The List of Products Along With The Tests is Mentioned Below :
Food Products: cereals, dairy products, meat, poultry products, fish, nuts, fruits and vegetables, sugar, honey, confectionery, oil, food additives, etc. are tested for microbial count, coliform, all pathogens, preservative efficacy, etc.
Water: samples from industries, sewage, swimming pool, potable water, drinking water and waste water are tested for coliform, streptococci, E.coli, pseudomonas aeruginosa and other pathogens, BOD, COD, TDS, TSS, grease content and several other parameters. Endo-toxin testing is also carried out in water samples.
Packaged drinking water and packaged natural mineral water are tested as per the protocols specified by IS: 14543 and IS: 13428.
Cosmetics Products: bacterial count, coliform, pseudomonas aeruginosa, salmonella, preservative efficacy, sterility, efficacy of ethylene oxide, etc.
...more